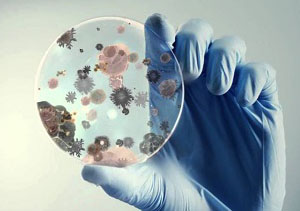

WHY HASSAN PARTNERS ?
Hassan & Partners Co LLC was established in Muscat, Oman in 1994. Since our founding, we have completed numerous projects and expanded our scope of work to include a variety of activities such as food industries, diagnostic regent (Manufacturing & Trade), industrial chemicals, laboratory, QC chemicals in bulk quantity, and we also offer a wide range of laboratory equipment, consumables, and process equipment products focused on various applications and market segments.
Full detailsPOPULAR PRODUCTS
Laboratory Chemicals
We are distributing top quality chemicals for your research and analytical use.
We supply QC standards, CRM from world best brand
Microbiology & General Lab Consumables
We offer complete and unique microbiological QC product and testing solutions for research, education, diagnostics, and medical applications.
Industrial chemicals
We are a semi-bulk distributor of fine industrial processing chemicals and biochemicals with our own warehousing facilities in Misfah, Muscat. We provide high-quality fine chemicals to your production. We provide the quickest shipping and delivery from our warehouse to anywhere in the world.